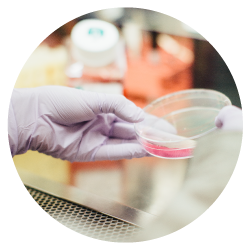

Fenuseeds® está respaldado por 32 estudios clínicos y 220 patentes internacionales. 100% natural, vegano, Halal, Kosher y soluble en agua. Certificados internacionalmente garantizando calidad y seguridad.
FenuSeeds se clasifica como un alimento bajo en calorías. 1 porción (30 g) = 30 calorías.
-

AUTENTICIDAD
Para garantizar la integridad del producto y mantener la trazabilidad, cada lote de semillas de fenogreco utilizado en el proceso se prueba con una sofisticada autenticación de especies basada en un código de barras de ADN.
-

CONTROL DE CALIDAD ESTRICTO
Las pruebas de control de calidad incluyen análisis químicos, físicos y biológicos a través de instrumentos como el cromatógrafo líquido de alto rendimiento (HPLC), el cromatógrafo de gases y el espectrómetro de masas de plasma acoplado inducido (ICP-MS).
-
SEGURIDAD
Garantizamos la seguridad de FENUSEEDS® para el consumo a largo plazo. FENUSEEDS® ha sido probado a través de rigurosos estudios toxicológicos y se ha demostrado que es seguro y no tiene efectos secundarios.
-

ACREDITACIONES
El ingrediente activo de FENUSEEDS® es natural, vegetariano y se fabrica en unas instalaciones que también cuentan con la certificación ISO 9001:2008 (Sistema de gestión de calidad) e ISO 22000 (Sistema de gestión de seguridad alimentaria). Se fabrica en unas instalaciones que cuentan con la certificación de los requisitos de Buenas prácticas de fabricación (BPF) de NSF International, EE. UU. [según la sección 8 de NSF/ANSI173 desarrollada de acuerdo con la parte 111 del título 21 del CFR de la FDA de EE. UU.]